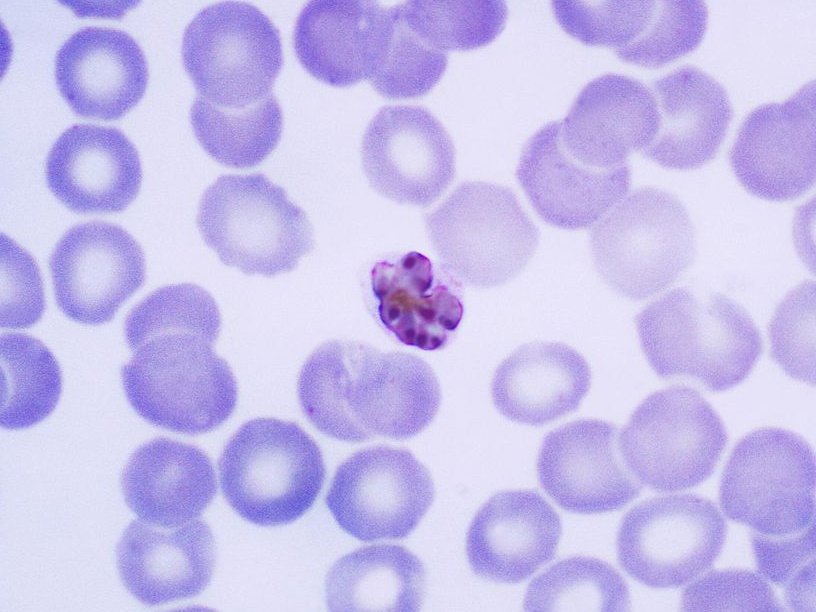

Вакцина от малярии показала обнадеживающие результаты на испытаниях
Экспериментальная вакцина, нацеленная на наиболее опасную форму возбудителя малярии, через год после начала испытаний в Западной Африке показала эффективность от 74 до 77 %. Это лучший результат, когда-либо достигнутый при попытках создать вакцину от этой болезни.
Затруднения с созданием вакцины от малярии имеют ту же причину, что и отсутствие стойкого иммунитета у переболевших. Дело в том, что малярийный плазмодий отличается сложным жизненным циклом и высокой частотой мутаций. Из-за этих мутаций структура белков на поверхности его клеток часто меняется, поэтому антитела, которые обеспечивают иммунитет, перестают эти клетки распознавать (подробнее об этом можно прочитать в специальном очерке).
В испытаниях вакцины, разработанной исследователями из Института Дженнера Оксфордского университета, участвовали дети в возрасте от 5 до 17 месяцев из Буркина-Фасо, где малярия является эндемическим заболеванием. Они получили три дозы вакцины с месячными интервалами и бустерную дозу через год. Дети из контрольной группы получали вакцину от бешенства (такой протокол испытания гарантирует, что контрольная группа тоже получит пользу от участия). Из 146 детей, получивших вакцину с высокой дозой иммуностимулирующего соединения, называемого адъювантом, малярией заболели 38. В контрольной группе заболели 105 из 147 детей. Эффективность вакцины с 77 % снизилась до 74 % у детей, получивших вакцину с более низкой дозой адъюванта. Уровень специфических антител к малярии у детей за год упал, но бустерная вакцинация восстановила его.
«Эффективность, которую мы получили, никогда не была достигнута ни одним кандидатом на вакцину против малярии. Это действительно потрясающие результаты», — говорит паразитолог Халиду Тинто (Halidou Tinto) из Института исследований в области здравоохранения в Наноро (Буркина-Фасо). Ранее лучшим результатом через год после вакцинации был иммунитет у 56 % (вакцина Mosquirix комании GlaxoSmithKline),через 4 года эффективность вакцины снизилась до 36 %. Статья с результатами испытаний публикуется в журнале The Lancet и уже доступна на его сервере препринтов.
Исследователи планируют начать в этом году третью фазу испытаний, где будут участвовать уже 4800 детей из Буркина-Фасо, Мали, Кении и Танзании. В случае успеха результаты могут быть представлены регулирующим органам в конце 2022 года. Как надеется руководитель исследований Адриан Хилл (Adrian Hill) из Оксфордского университета, если третья фаза подтвердит высокий уровень эффективности вакцины, регулирующие органы могут выдать разрешение на использование ее в особом порядке, как это было сделано для вакцин против COVID-19.